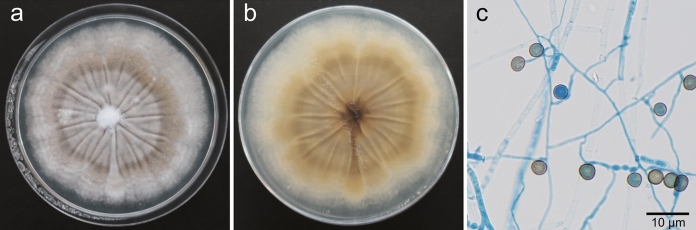

撒丁Humicola sardiniae引起的真菌性角膜炎。
IF 2.9
3区 生物学
Q2 MYCOLOGY
引用次数: 0
摘要
本文章由计算机程序翻译,如有差异,请以英文原文为准。

Fungal Keratitis Caused by Humicola sardiniae.
求助全文
通过发布文献求助,成功后即可免费获取论文全文。
去求助
来源期刊

Mycopathologia
生物-真菌学
CiteScore
6.80
自引率
3.60%
发文量
76
审稿时长
3 months
期刊介绍:
Mycopathologia is an official journal of the International Union of Microbiological Societies (IUMS). Mycopathologia was founded in 1938 with the mission to ‘diffuse the understanding of fungal diseases in man and animals among mycologists’. Many of the milestones discoveries in the field of medical mycology have been communicated through the pages of this journal. Mycopathologia covers a diverse, interdisciplinary range of topics that is unique in breadth and depth. The journal publishes peer-reviewed, original articles highlighting important developments concerning medically important fungi and fungal diseases. The journal highlights important developments in fungal systematics and taxonomy, laboratory diagnosis of fungal infections, antifungal drugs, clinical presentation and treatment, and epidemiology of fungal diseases globally. Timely opinion articles, mini-reviews, and other communications are usually invited at the discretion of the editorial board. Unique case reports highlighting unprecedented progress in the diagnosis and treatment of fungal infections, are published in every issue of the journal. MycopathologiaIMAGE is another regular feature for a brief clinical report of potential interest to a mixed audience of physicians and laboratory scientists. MycopathologiaGENOME is designed for the rapid publication of new genomes of human and animal pathogenic fungi using a checklist-based, standardized format.
 求助内容:
求助内容: 应助结果提醒方式:
应助结果提醒方式:


